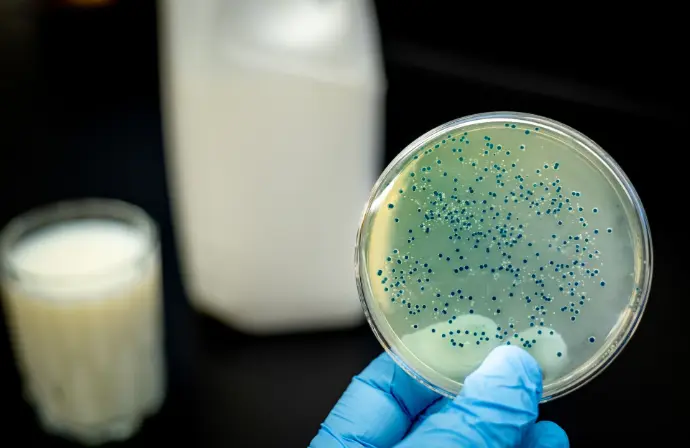

CRISPR Revolutionizes How Scientists View the Genome![]()
CRISPR has allowed scientists to execute microsurgeries on not just bacteria genomes but also animal genomes. The CRISPR technology opens the gateway to identifying and curing genome defects and diseases. It has the potential to reverse the effects of diseases like sickle cell anemia, cystic fibrosis, and HIV.
This technology could allow researchers to perform microsurgery on genes, precisely and easily changing a DNA sequence at exact locations on a chromosome. Along with a technique called TALENs, invented several years ago, and a slightly older predecessor based on molecules called zinc finger nucleases, CRISPR could make gene therapies more broadly applicable, providing remedies for simple genetic disorders like sickle-cell anemia and eventually even leading to cures for more complex diseases involving multiple genes. Most conventional gene therapies crudely place new genetic material at a random location in the cell and can only add a gene. In contrast, CRISPR and the other new tools also give scientists a precise way to delete and edit specific bits of DNA—even by changing a single base pair. This means they can rewrite the human genome at will.
Synthetic Biology Starting Up in American Universities
A team of scientists, with very diverse research backgrounds, from Northwestern University have come together to study the rapidly developing field of Synthetic Biology. They hope to find within Synthetic Biology answers to health and fuel problems occurring in the world today.
The work of the synthetic biologists is directly in line with at least two of the pillars of Northwestern’s 2011 Strategic Plan. It underscores the University’s mission to “discover creative solutions” by working together through research and innovation to find answers to problems “that will improve lives, communities and the world.” It also evokes Northwestern’s priority to “engage with the world” through strategic partnerships in order “to heighten our global impact for the greater good.”
Monkey See Monkey Do: Genetically Engineering Monkeys
Gene editing has become faster and easier through the use of Cas9/CRISPR, and has been implemented in the genetic engineering of macaques monkeys.
The main purpose of the Cell study was to prove that CRISPR technology can be made to work in macaque monkeys—an especially important goal because macaques have become the new stand-in for people now that chimpanzees are being used less frequently for medical research.- Christine Gorman
Genetic Engineering Creates Hope for Incurable Blindness
Professor Robert E. Mcclean and his team of researchers from Oxford University, using gene therapy, have improved conditions of patients living with choroideremia, a severe genetic defect that causes blindness.
Six months after the injections, the team conducting the trial found the retinas in all of the patients had improved sensitivity to light and that two patients had substantially improved vision. These two patients had the most advanced form of choroideremia, and after they received the treatment they were able to correctly read an extra two and four lines on an eye chart, respectively. No adverse effects from the injection were recorded in the trial.
Synthetic Biology in a New World
When Craig Venter created a new living creature using biotechnology by assembling real DNA based on computer information, he became known as the most powerful and influential man in biotechnology. By creating an organism that can replicate itself, he explained that as the technology advances, we will be able to develop robotics and computational systems that are self-learning systems. However, there are huge concerns for national security and public health that surround biotechnology.
When Venter’s team first created the phi X174 viral genome, Venter commissioned a large analysis of the implications of synthetic genomics for national security and public health. The resulting report warned that two issues were impeding appropriate governance of the new science. The first problem was that work on synthetic biology, or synbio, had become so cheap and easy that its practitioners were no longer classically trained biologists. This meant that there were no shared assumptions regarding the new field’s ethics, professional standards, or safety. The second problem was that existing standards, in some cases regulated by government agencies in the United States and other developed countries, were a generation old, therefore outdated, and also largely unknown to many younger practitioners.
Einstein’s revolutionary theories helped unravel the secrets of the cosmos. They also led to the atom bomb.
Bacteria Factories
A new study conducted at the Wyss institute at Harvard has discovered a way to design bacteria cells to produce specific types and amounts [...]
Bacteria FactoriesÉxito Hearts Assessment February 2020: Scam or perhaps Real Occassions?: February 07, 2020As men, we’ve a lot of cleaning as much as do seeing that an entire in terms of how we [...]Genome Compiler – The Platform for Synthetic Biology Tools Welcomes DNA2.0 as a Premium Synthesis PartnerGenome Compiler – The Platform for Synthetic Biology Tools Welcomes DNA2.0 as a Premium Synthesis Partner: November 14, 2014Los Altos, CA and Menlo Park, CA (November 14, 2014). Genome Compiler Corp., a Los Altos based synthetic biology
We create the perfect
tailored solution for you
Secured
Tell what's the value for the
customer for this feature.
All in one
Write what the customer would like to know,
not what you want to show.
Easy to use
A small explanation of this great
feature, in clear words.
Our mission
Provide clear and concise financial advices to make your financial wealth grow. And this, completely free of charge.
Our values
We created our company to improve the work-life balance. We believe that we need to focus on our family more than our work and finances.
Our team
Composed of 25 people from 25 to 66 years, we’re a young and dynamic company. We have open positions, do not hesitate to contact us.